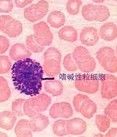
嗜鹼性粒細胞和肥大細胞 嗜鹼性粒細胞和肥大細胞

內容
嗜鹼性粒細胞是粒細胞的一種,存在血液中,占血液白細胞總數的0.5%。肥大細胞存在組織內,分布在呼吸道、消化道黏膜及皮膚、漿膜、血管、淋巴管、末梢神經周圍的結締組織中,此外,胸腺、淋巴結和關節骨膜也有肥大細胞。這二種細胞的形態和分布不同,但胞質中都含有嗜鹼性顆粒。它們的功能很相似,都是引起免疫損傷(特別是I型變態反應)的效應細胞,都常一併描述。在生理情況下,它們通過其釋放的介質──組胺、肝素以及分泌的細胞因子──白細胞介素3、4、5、6、GM-CSF等參與免疫調節、抗凝、組織修復等生理活動。
細胞的起源和異源性 嗜鹼性粒細胞起源於骨髓造血多能幹細胞,在骨髓內分化成熟後進入血流。肥大細胞的來源尚有爭議,目前,人類肥大細胞的起源以及肥大細胞與嗜鹼性粒細胞之間的關係仍不清楚。已確知 α鼠肥大細胞來自骨髓的造血多能幹細胞,在各種組織的微環境內成熟,形成結締組織肥大細胞和黏膜肥大細胞。結締組織肥大細胞體積較大,胞質顆粒多,組胺含量高,對藥物比較敏感。
細胞的形態和結構 嗜鹼性粒細胞呈圓形,直徑10~14μm,胞核分葉不清楚,胞質含形狀不規則、大小不等的嗜鹼性顆粒,用甲苯胺藍染色,顆粒由藍變紫,稱為異染性,大顆粒直徑可達 1.2μm,易溶於水。電子顯微鏡下,顆粒內含物電子密度較高。胞質有複雜的囊泡,豐富的糖原。其他細胞器都不明顯。
肥大細胞呈圓形、卵圓形、三角形或不規則的四邊形,細胞直徑 5~25μm,胞核圓形,偶見雙核。胞質充滿圓形嗜鹼性顆粒,顆粒多而密集,直徑0.2~0.5μm可溶於水,也有異染性,電鏡下,細胞表面有絲狀偽足,胞質顆粒內部有格柵狀結晶或指紋狀結構,胞質中有線粒體及豐富的戈爾吉氏器,顆粒之間有粗面內質網。
嗜鹼性粒細胞和肥大細胞表面有高親和性的 IgEFc受體(FcεR)、FcεR由α,β,γ 三條肽鏈組成,α 鏈與IgEFc 段結合, 每個嗜鹼性粒細胞有2×105FcεR、每個肥大細胞有5×103~2×104FcεR。
生物活性介質 嗜鹼性粒細胞和肥大細胞的嗜鹼性顆粒中含幾十種生物活性介質。顆粒中固有的生物活性介質有生物胺、糖蛋白、中性蛋白酶等等,細胞活化過程中新形成的介質有前列腺素、白細胞三烯、血小板活化因子等等。生物胺中以組胺含量最多。
①組胺。分子量111,體內的組胺主要來自肥大細胞和嗜鹼性粒細胞。人類肥大細胞含組胺 1~15μg/106細胞,嗜鹼性粒細胞為 1~3μg/106細胞。細胞內組胺含量受細胞本身成熟程度、機體的營養狀況以及細胞活化的不同時期等多種因素影響。體內許多細胞具有組胺受體,包括受體1(H1)和受體2(H2),它們與組胺結合後可產生不同的生物學效應。
②肝素。分子量60000,內源性肝素主要來自肥大細胞。肝素有抗凝和抗補體活性作用,並可通過組織細胞參與脂類攝取,刺激毛細血管內皮細胞移行,在局部血管修復和再生中有重要作用。肝素的生物學作用可被精蛋白,嗜酸性粒細胞主要鹼性蛋白及血小板因子4(PF4)中和。
③白細胞三烯(LT)。肥大細胞活化過程中,花生四烯酸經脂氧化酶途徑,代謝形成白細胞三烯,這是一類低分子量酸性脂類物質(分子量400~500)。慢反應物質(SRS-A)與LT(LTC4,LTD4,LTE4)是同一類物質,它們能緩慢而持久地引起平滑肌收縮,是支氣管哮喘發病的主要介質。
④前列腺素(PG)。是二十碳脂肪酸。肥大細胞活化過程中產生前列腺素PGE2和PGD2,使小血管擴張,通透性增高,對疼痛敏感,PGD2還引起支氣管收縮,抑制血小板聚集,促進嗜鹼性粒細胞釋放組胺。阿斯匹林可影響前列腺素的代謝。
⑤嗜酸性粒細胞趨化因子(ECF-A)。是酸性四肽,分子量 500~1000。對嗜酸性粒細胞有趨化作用,能使其表面表達更多的 C3b受體,以增強嗜酸性粒細胞的免疫功能,維生素C可增強ECF-A的作用。
脫顆粒 經典的嗜鹼性粒細胞和肥大細胞的活化和脫顆粒現象是由過敏原誘導的,過敏原與結合在細胞表面的IgE(或IgG4)作用形成橋狀結構,引起膜表面IgEFc受體(FcεR)聚集,蛋白酶被激活, 其中甲基轉移酶使膜磷脂甲基化形成磷酸膽鹼、鈣離子內流,活化磷脂酶A2。磷脂酶A2可誘導細胞脫顆粒, 釋放組胺。FcεR聚集可刺激腺苷環化酶,使細胞環腺苷酸(cAMP)水平增高,細胞內cAMP和鈣離子共同調節細胞的脫顆粒過程。脫顆粒的最適溫度為37℃,在此過程中尚需糖原分解提供能量。電子顯微鏡觀察可見細胞內顆粒腫脹,顆粒膜與細胞膜融合形成與外界相通的通道,顆粒內容物溶解,釋放出生物活性介質。顆粒脫出後形成細胞內的空隙,因流入液體填充空隙,細胞不受損害。
植物血凝素(PHA)、刀豆素A(ConA)、抗 IgE抗體、抗 FcεR抗體等均可誘導 FcεR聚集,導致嗜鹼性粒細胞和胞大細胞脫顆粒。這些因素包括,神經肽(快速激肽,神經緊張肽,生長激素釋放因子等)、過敏毒素(C3a、C4a 、C5a)、白細胞衍生物,組胺釋放因子以及某些診斷或治療性藥物,如β-受體阻斷藥、膽鹼受體刺激藥、H2組胺受體阻滯藥等;某些生理性刺激如低氧、陽光、熱、冷、甚至外傷等也可導致肥大細胞脫顆粒。非免疫性因素也可引起肥大細胞脫顆粒作用,在哮喘發病中相當重要。
嗜鹼性粒細胞和肥大細胞的生理功能是通過細胞活化釋放生物活性介質完成的。若短時間內釋放大量生物活性介質,即可造成病理損傷mml">配圖
所屬分類
免疫細胞免疫